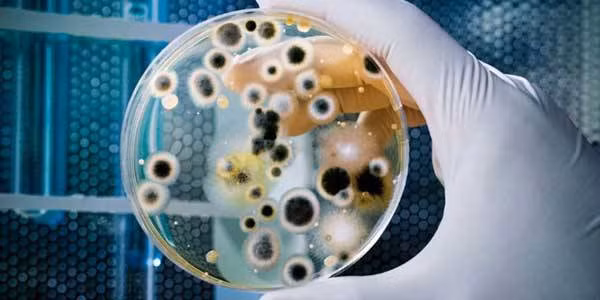
Chính chúng ta đang tạo ra siêu vi khuẩn “3 giây giết 1 người” như thế nào?

|









GD&TĐ - Những xe bọc thép chở quân sử dụng khung gầm xe tăng chiến đấu chủ lực có lẽ là phương tiện cần thiết với Quân đội Nga hiện nay.

GD&TĐ - Các nguồn thông tin mở cho biết đến năm 2018, Nga có thể vẫn lưu giữ tới 130 tiêm kích MiG-31 trong các kho dự trữ.

GD&TĐ - Quân đội Nga có kho vũ khí pháo lớn nhất và cũng có nguồn cung cấp đạn dược ổn định – Tạp chí Forbes tuyên bố ngày 16/7.

GD&TĐ - Xe tăng chiến đấu chủ lực T-90M do Nga sản xuất đã trở thành một trong những phương tiện chủ chốt trong chiến dịch quân sự đặc biệt ở Ukraine.

GD&TĐ - Cấu hình mới của tàu đổ bộ Dự án 11711 mang lại khả năng tác chiến cao hơn cho Hải quân Nga.

GD&TĐ - Dù điều kiện học tập có phần hạn chế nhưng, Dương Đình Thanh người dân tộc Tày vẫn sở hữu điểm số ba môn Toán, Vật lí và tiếng Anh vô cùng ấn tượng.

GD&TĐ - Trong ngày, tình trạng ngừng hoạt động của các thiết bị máy tính chạy Windows được báo cáo ở nhiều quốc gia khác nhau.












GD&TĐ - Công an phường Hồng Gai (Quảng Ninh) vừa tổ chức tuyên truyền phòng, chống đuối nước cho trẻ em dịp hè.

GD&TĐ - Xem lịch âm ngày 24/6/2026. Xem ngày tốt xấu, giờ đẹp xuất hành, khai trương, động thổ...

GD&TĐ - Chi đoàn Công an xã Đường Hoa (Quảng Ninh) phối hợp Đoàn Thanh niên xã hỗ trợ thí sinh trong Kỳ thi tuyển sinh vào lớp 10 năm học 2026 – 2027.

GD&TĐ - Trạm Y tế xã Ba Chẽ (Quảng Ninh) vừa phối hợp với Trường Mầm non Đồn Đạc tổ chức tuyên truyền phòng, chống bệnh tay chân miệng.

GD&TĐ - Bộ trưởng Bộ GD&ĐT Hoàng Minh Sơn đã ký quyết định bổ nhiệm PGS.TS Nguyễn Thị Thu Hằng giữ chức vụ Giám đốc Học viện Quản lý giáo dục.

GD&TĐ - Một công ty Israel vừa công bố hệ thống laser với cách đánh chặn khác biệt, hướng tới đối phó các cuộc tập kích UAV quy mô lớn.

GD&TĐ - Cristiano Ronaldo bước vào trận đấu giữa Bồ Đào Nha và Uzbekistan tại World Cup 2026 với áp lực không nhỏ.

GD&TĐ - Trong thông điệp gửi một diễn đàn quốc tế, Tổng thống Nga Vladimir Putin đưa ra những chỉ trích đối với "luật lệ" của phương Tây.

GD&TĐ - Với lối chơi thích kiểm soát thế trận và thường xuyên đẩy cao đội hình của tuyển Anh, Ghana được cảnh báo là đối thủ không thể xem nhẹ.

GD&TĐ - Bộ GD&ĐT đang lấy ý kiến đối với dự thảo Nghị định quy định xử phạt vi phạm hành chính trong lĩnh vực giáo dục (Dự thảo).

GD&TĐ - Bên cạnh việc bảo đảm số lượng tuyển sinh, các trung tâm GDNN-GDTX và trường trung cấp nghề ở Nghệ An đang chú trọng cân bằng về chất lượng.

GD&TĐ - Ibrahim Maza tiếp tục tạo nên dấu ấn tại World Cup 2026 khi được trao danh hiệu Cầu thủ xuất sắc nhất trận sau chiến thắng 2-1 của Algeria.